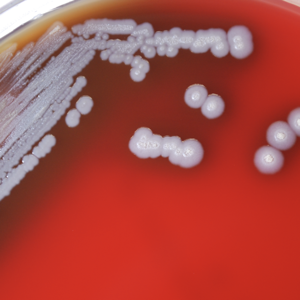

By IDSE News Staff
Researchers have detected anaerobic and aerobic bacteria in commercial tattoo and permanent makeup inks, which means they could be a source of human infection (Appl Environ Microbiol 2024 Jul 2. doi:10.1128/aem.00276-24).

This is the first time anaerobic bacteria were found in commercial tattoo inks, the microbiologists said.
“Our findings reveal that unopened and sealed tattoo inks can harbor anaerobic bacteria, known to thrive in low-oxygen environments like the dermal layer of the skin, alongside aerobic bacteria,” said corresponding author Seong-Jae (Peter) Kim, PhD, a microbiologist with the FDA’s National Center for Toxicological Research, Division of Microbiology in Jefferson, Ark. “This suggests that contaminated tattoo inks could be a source of infection from both types of bacteria. The results emphasize the importance of monitoring these products for both aerobic and anaerobic bacteria, including possibly pathogenic microorganisms.”
The main goal of the new study was to assess the prevalence of both aerobic and anaerobic microbial contaminants in tattoo inks available on the U.S. market. For the detection of aerobic bacteria, the researchers mixed 1 to 2 g of tattoo ink solution with appropriate media and incubated them in a standard incubator; to detect anaerobic bacteria, they mixed the ink solution with appropriate media and incubated them in an anaerobic chamber, a device specifically designed to cultivate anaerobes. This chamber is kept oxygen-free by constant flushing with a mix of gases, such as nitrogen, carbon dioxide and hydrogen. The researchers conducted this procedure for 75 tattoo inks from 14 different manufacturers.
About 35% of tattoo or permanent makeup inks sold in the United States were found to be contaminated with bacteria. “Both types of bacteria, those needing oxygen and those not needing oxygen, can contaminate the inks,” Dr. Kim said. “There was no clear link between a product label claiming sterility and the actual absence of bacterial contamination.
“The rising popularity of tattooing in recent years has coincided with an increase in tattoo-related complications or adverse reactions,” Dr. Kim said. “It should be noted that microbial infections constitute just one aspect of these complications. In addition to microbial infections, immunologic complications, such as inflammatory reactions and allergic hypersensitivity, as well as toxic responses, represent a significant portion of these issues. In light of our study results, we want to emphasize the importance of continuously monitoring these products to ensure the microbial safety of tattoo inks.”
Dr. Kim and his colleagues will move their research forward in two key directions. They will develop more efficient microbial detection methods for tattoo inks, making the process quicker, more accurate and less labor-intensive. They will also conduct systematic research to deepen the understanding of microbial contamination in tattoo and permanent makeup inks. This will include studying the occurrence, co-occurrence and diversity of microbial contaminants, which is essential for preventing contamination in these products.